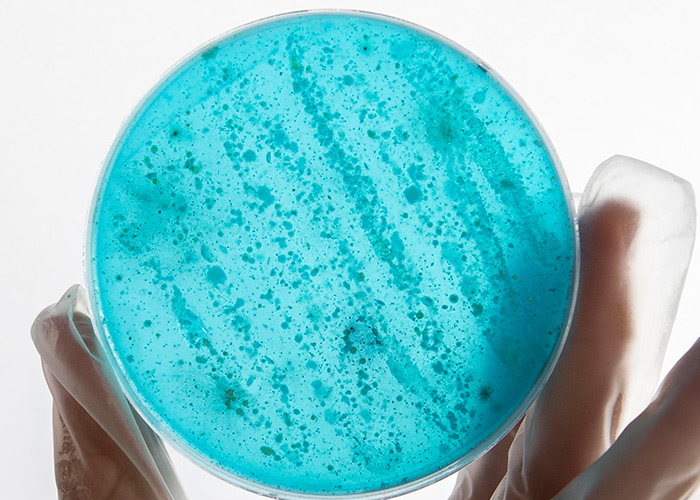

A obesidade é uma doença que tem aumentado em todo o mundo. No Brasil, aproximadamente 60% dos adultos apresentam excesso de peso, o que representa cerca de 96 milhões de pessoas. Além disso, um em cada quatro brasileiros tem obesidade, somando mais de 41 milhões de indivíduos, segundo a Pesquisa Nacional de Saúde (PNS/2020). […]
Mês: abril 2024
LcS no desempenho
Hiroko Kikuchi-Hayakawa1, Hiroshi Ishikawa1, Kazunori Suda1,2, Yusuke Gondo1, Genki Hirasawa1, Hayato Nakamura1, Mai Takada1, Mitsuhisa Kawai1 e Kazunori Matsuda1 1 Yakult Central Institute, 5-11 Izumi, Kunitachi-shi, Tokyo 186-8650, Japan 2 Yakult Honsha European Research Center for Microbiology VOF, Ghent, Belgium A exposição ao estresse psicológico causa vários distúrbios físicos e mentais através do sistema […]
Pausa importante
O silêncio pode ser considerado um instrumento de autoconhecimento, pois fornece a cada indivíduo tempo para pensar, observar, sentir, aprender e evoluir. Através do silêncio é possível ter a atenção voltada aos próprios pensamentos, às emoções e reações físicas e emocionais. No silêncio também é possível identificar as próprias dores, angústias, forças, alegrias e […]
Nova alegação
A Organização Mundial da Saúde (OMS) classifica probióticos como ‘microrganismos vivos que, quando administrados em quantidades adequadas, conferem algum benefício para a saúde’. Esses microrganismos pertencem a diferentes gêneros e espécies, tanto de bactérias como de leveduras. Em 2001, o Leite Fermentado Yakult foi o primeiro leite fermentado fabricado no Brasil a ser aprovado […]
Doença carece
A médica Isabela Maria Bernardes Goulart ressalta que o diagnóstico precoce e o tratamento oportuno são dificultados pelo estigma, pela falta de informação sobre a doença e, principalmente, pela qualificação inadequada de profissionais da saúde. “A hanseníase não recebe a devida atenção, mesmo durante a graduação. E isso se reflete na prática clínica, pois […]
Tratamento adequado pode
O tratamento de acordo com o Protocolo Clínico e Diretrizes Terapêuticas (PCDT) do Ministério da Saúde é oferecido em nível ambulatorial exclusivamente nas unidades básicas de saúde, priorizando a atenção integral ao paciente por meio do monitoramento terapêutico e de medidas para restabelecer o bem-estar físico, psíquico, emocional e social. Recomendada pela Organização Mundial […]
Potenciais biomarcadores para
Apesar de ser uma enfermidade antiga, existe uma grande limitação em relação a testes laboratoriais com alto desempenho e baixo custo para diagnóstico da hanseníase. Recentemente, pesquisadores da Faculdade de Medicina de Ribeirão Preto da Universidade de São Paulo (FMRP-USP) identificaram biomarcadores para rastreio, diagnóstico e monitoramento da doença. Realizado no Centro de Referência […]
Experimento avalia o trânsito
Em um estudo conduzido pela disciplina de Gastroenterologia Pediátrica do Departamento de Pediatria da EPM-Unifesp – sob a coordenação do professor doutor Mauro Batista de Morais –, a médica Marcela Duarte de Sillos e outros pesquisadores avaliaram o tempo de trânsito colônico total e segmentar em crianças e adolescentes com fibrose cística, segundo a […]
Estudos sugerem
A grande atenção que tem sido dada ao estudo da microbiota intestinal em indivíduos com fibrose cística também se justifica porque a doença cursa com infecções de repetição e inflamação que, associadas ao uso contínuo de antibióticos, podem provocar alterações negativas na microbiota intestinal. Atualmente, já há estudos mostrando alteração na microbiota intestinal de […]